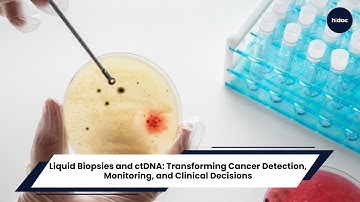
Liquid Biopsies and ctDNA: Transforming Cancer Detection, Monitoring, and Clinical Decisions

⬇ DOWNLOAD NOW
Jika muncul iklan pop-up, tutup lalu klik tombol kembali
Download lagu ctDNA in Oncology: Transforming MRD Assessment, Disease Tracking, and Early Cancer Detection secara gratis hanya untuk keperluan promosi. Dukung artis favorit kamu dengan membeli musik original di iTunes atau platform resmi lainnya.
 The Emerging Role of Circulating Tumor DNA (ctDNA) in Ovarian Cancer Care
The Emerging Role of Circulating Tumor DNA (ctDNA) in Ovarian Cancer Care Understand ctDNA Testing
Understand ctDNA Testing Using circulating tumor DNA (ctDNA) for the early detection of cancer.
Using circulating tumor DNA (ctDNA) for the early detection of cancer. 2025 HOPA Conference: Utility of Circulating Tumor DNA ctDNA Across the Cancer Care Continuum
2025 HOPA Conference: Utility of Circulating Tumor DNA ctDNA Across the Cancer Care Continuum Liquid Biopsies and ctDNA: Transforming Cancer Detection, Monitoring, and Clinical Decisions
Liquid Biopsies and ctDNA: Transforming Cancer Detection, Monitoring, and Clinical Decisions What is Circulating Tumor DNA (ctDNA)?
What is Circulating Tumor DNA (ctDNA)? Circulating Tumor DNA (ctDNA) Sequencing: Liquid Biopsy for Cancer Detection & Monitoring
Circulating Tumor DNA (ctDNA) Sequencing: Liquid Biopsy for Cancer Detection & Monitoring ctDNA and MRD | 2023 Best of GI Cancer Conference
ctDNA and MRD | 2023 Best of GI Cancer Conference